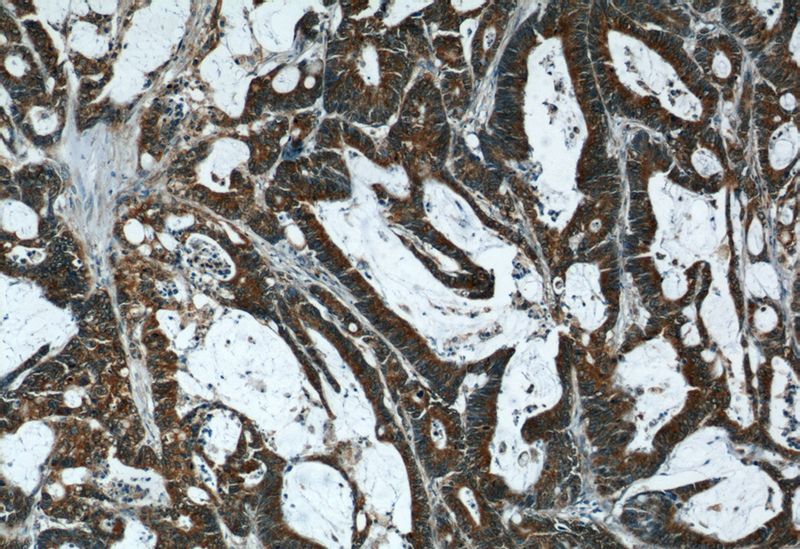
Immunohistochemical of paraffin-embedded human colon cancer using Catalog No:110363(ERK1 antibody) at dilution of 1:50 (under 10x lens)

-
Product Name
ERK1/2 antibody
- Documents
-
Description
ERK1/2 Rabbit Polyclonal antibody. Positive WB detected in HeLa cells, A375 cells, A549 cells, HepG2 cells, HepG2/A431 cells, Jurkat cells, mouse lung tissue. Positive IHC detected in human colon cancer tissue, human breast cancer tissue, human prostate cancer tissue, human prostate hyperplasia tissue. Positive IF detected in A375 cells, MCF-7 cells, PC-3 cells. Observed molecular weight by Western-blot: 38-44 kDa
-
Tested applications
ELISA, IHC, IF, WB
-
Species reactivity
Human, Mouse; other species not tested.
-
Alternative names
ERK antibody; ERK 1 antibody; ERK1 antibody; ERK1/2 antibody; ERT2 antibody; HS44KDAP antibody; HUMKER1A antibody; Insulin stimulated MAP2 kinase antibody; MAP kinase 1 antibody; MAP kinase 3 antibody; MAP kinase isoform p44 antibody; MAPK 1 antibody; MAPK 3 antibody; MAPK3 antibody; p44 ERK1 antibody; p44 MAPK antibody; P44ERK1 antibody; P44MAPK antibody; PRKM3 antibody
- Immunogen
-
Isotype
Rabbit IgG
-
Preparation
This antibody was obtained by immunization of ERK1/2 recombinant protein (Accession Number: NM_002746). Purification method: Antigen affinity purified.
-
Clonality
Polyclonal
-
Formulation
PBS with 0.1% sodium azide and 50% glycerol pH 7.3.
-
Storage instructions
Store at -20℃. DO NOT ALIQUOT
-
Applications
Recommended Dilution:
WB: 1:200-1:1000
IHC: 1:20-1:200
IF: 1:10-1:100
-
Validations

WB result of Catalog No:110363 (ERK1 antibody) with various lysates at dilution of 1:1000.

HeLa cells were subjected to SDS PAGE followed by western blot with Catalog No:110363(ERK1 antibody) at dilution of 1:300
Immunohistochemical of paraffin-embedded human colon cancer using Catalog No:110363(ERK1 antibody) at dilution of 1:50 (under 10x lens)

Immunohistochemical of paraffin-embedded human colon cancer using Catalog No:110363(ERK1 antibody) at dilution of 1:50 (under 40x lens)

Immunofluorescent analysis of A375 cells using Catalog No:110363(ERK1/2 Antibody) at dilution of 1:25 and Alexa Fluor 488-congugated AffiniPure Goat Anti-Rabbit IgG(H+L)
-
Background
ERK1 and ERK2 belongs to the protein kinase superfamily. It is involved in both the initiation and regulation of meiosis, mitosis, and postmitotic functions in differentiated cells by phosphorylating a number of transcription factors such as ELK-1. ERK1/2 catalized the reaction: ATP + a protein = ADP + a phosphoprotein. It is activated by tyrosine phosphorylation in response to insulin and NGF. This antibody can recognize both ERK1 and ERK2.
-
References
- Liu C, Liu Y, Xu XX. Potential effect of matrix stiffness on the enrichment of tumor initiating cells under three-dimensional culture conditions. Experimental cell research. 330(1):123-34. 2015.
- Su CC, Chen JY, Din ZH. 13-acetoxysarcocrassolide induces apoptosis on human gastric carcinoma cells through mitochondria-related apoptotic pathways: p38/JNK activation and PI3K/AKT suppression. Marine drugs. 12(10):5295-315. 2014.
- Shi L, Zhang S, Wu H. MiR-200c increases the radiosensitivity of non-small-cell lung cancer cell line A549 by targeting VEGF-VEGFR2 pathway. PloS one. 8(10):e78344. 2013.
- Li X, Zhao H, Wang Q, Liang H, Jiang X. Fucoidan protects ARPE-19 cells from oxidative stress via normalization of reactive oxygen species generation through the Ca²⁺-dependent ERK signaling pathway. Molecular medicine reports. 11(5):3746-52. 2015.
- Shi M, He X, Wei W, Wang J, Zhang T, Shen X. Tenascin-C induces resistance to apoptosis in pancreatic cancer cell through activation of ERK/NF-κB pathway. Apoptosis : an international journal on programmed cell death. 20(6):843-57. 2015.
- Zhang P, Feng S, Bai H. Polychlorinated biphenyl quinone induces endothelial barrier dysregulation by setting the cross talk between VE-cadherin, focal adhesion, and MAPK signaling. American journal of physiology. Heart and circulatory physiology. 308(10):H1205-14. 2015.
- Li XL, Chen XQ, Zhang MN. SOX9 was involved in TKIs resistance in renal cell carcinoma via Raf/MEK/ERK signaling pathway. International journal of clinical and experimental pathology. 8(4):3871-81. 2015.
- Dai XF, Ding J, Zhang RG, Ren JH, Ma CM, Wu G. Radiosensitivity enhancement of human hepatocellular carcinoma cell line SMMC-7721 by sorafenib through the MEK/ERK signal pathway. International journal of radiation biology. 89(9):724-31. 2013.
Related Products / Services
Please note: All products are "FOR RESEARCH USE ONLY AND ARE NOT INTENDED FOR DIAGNOSTIC OR THERAPEUTIC USE"
